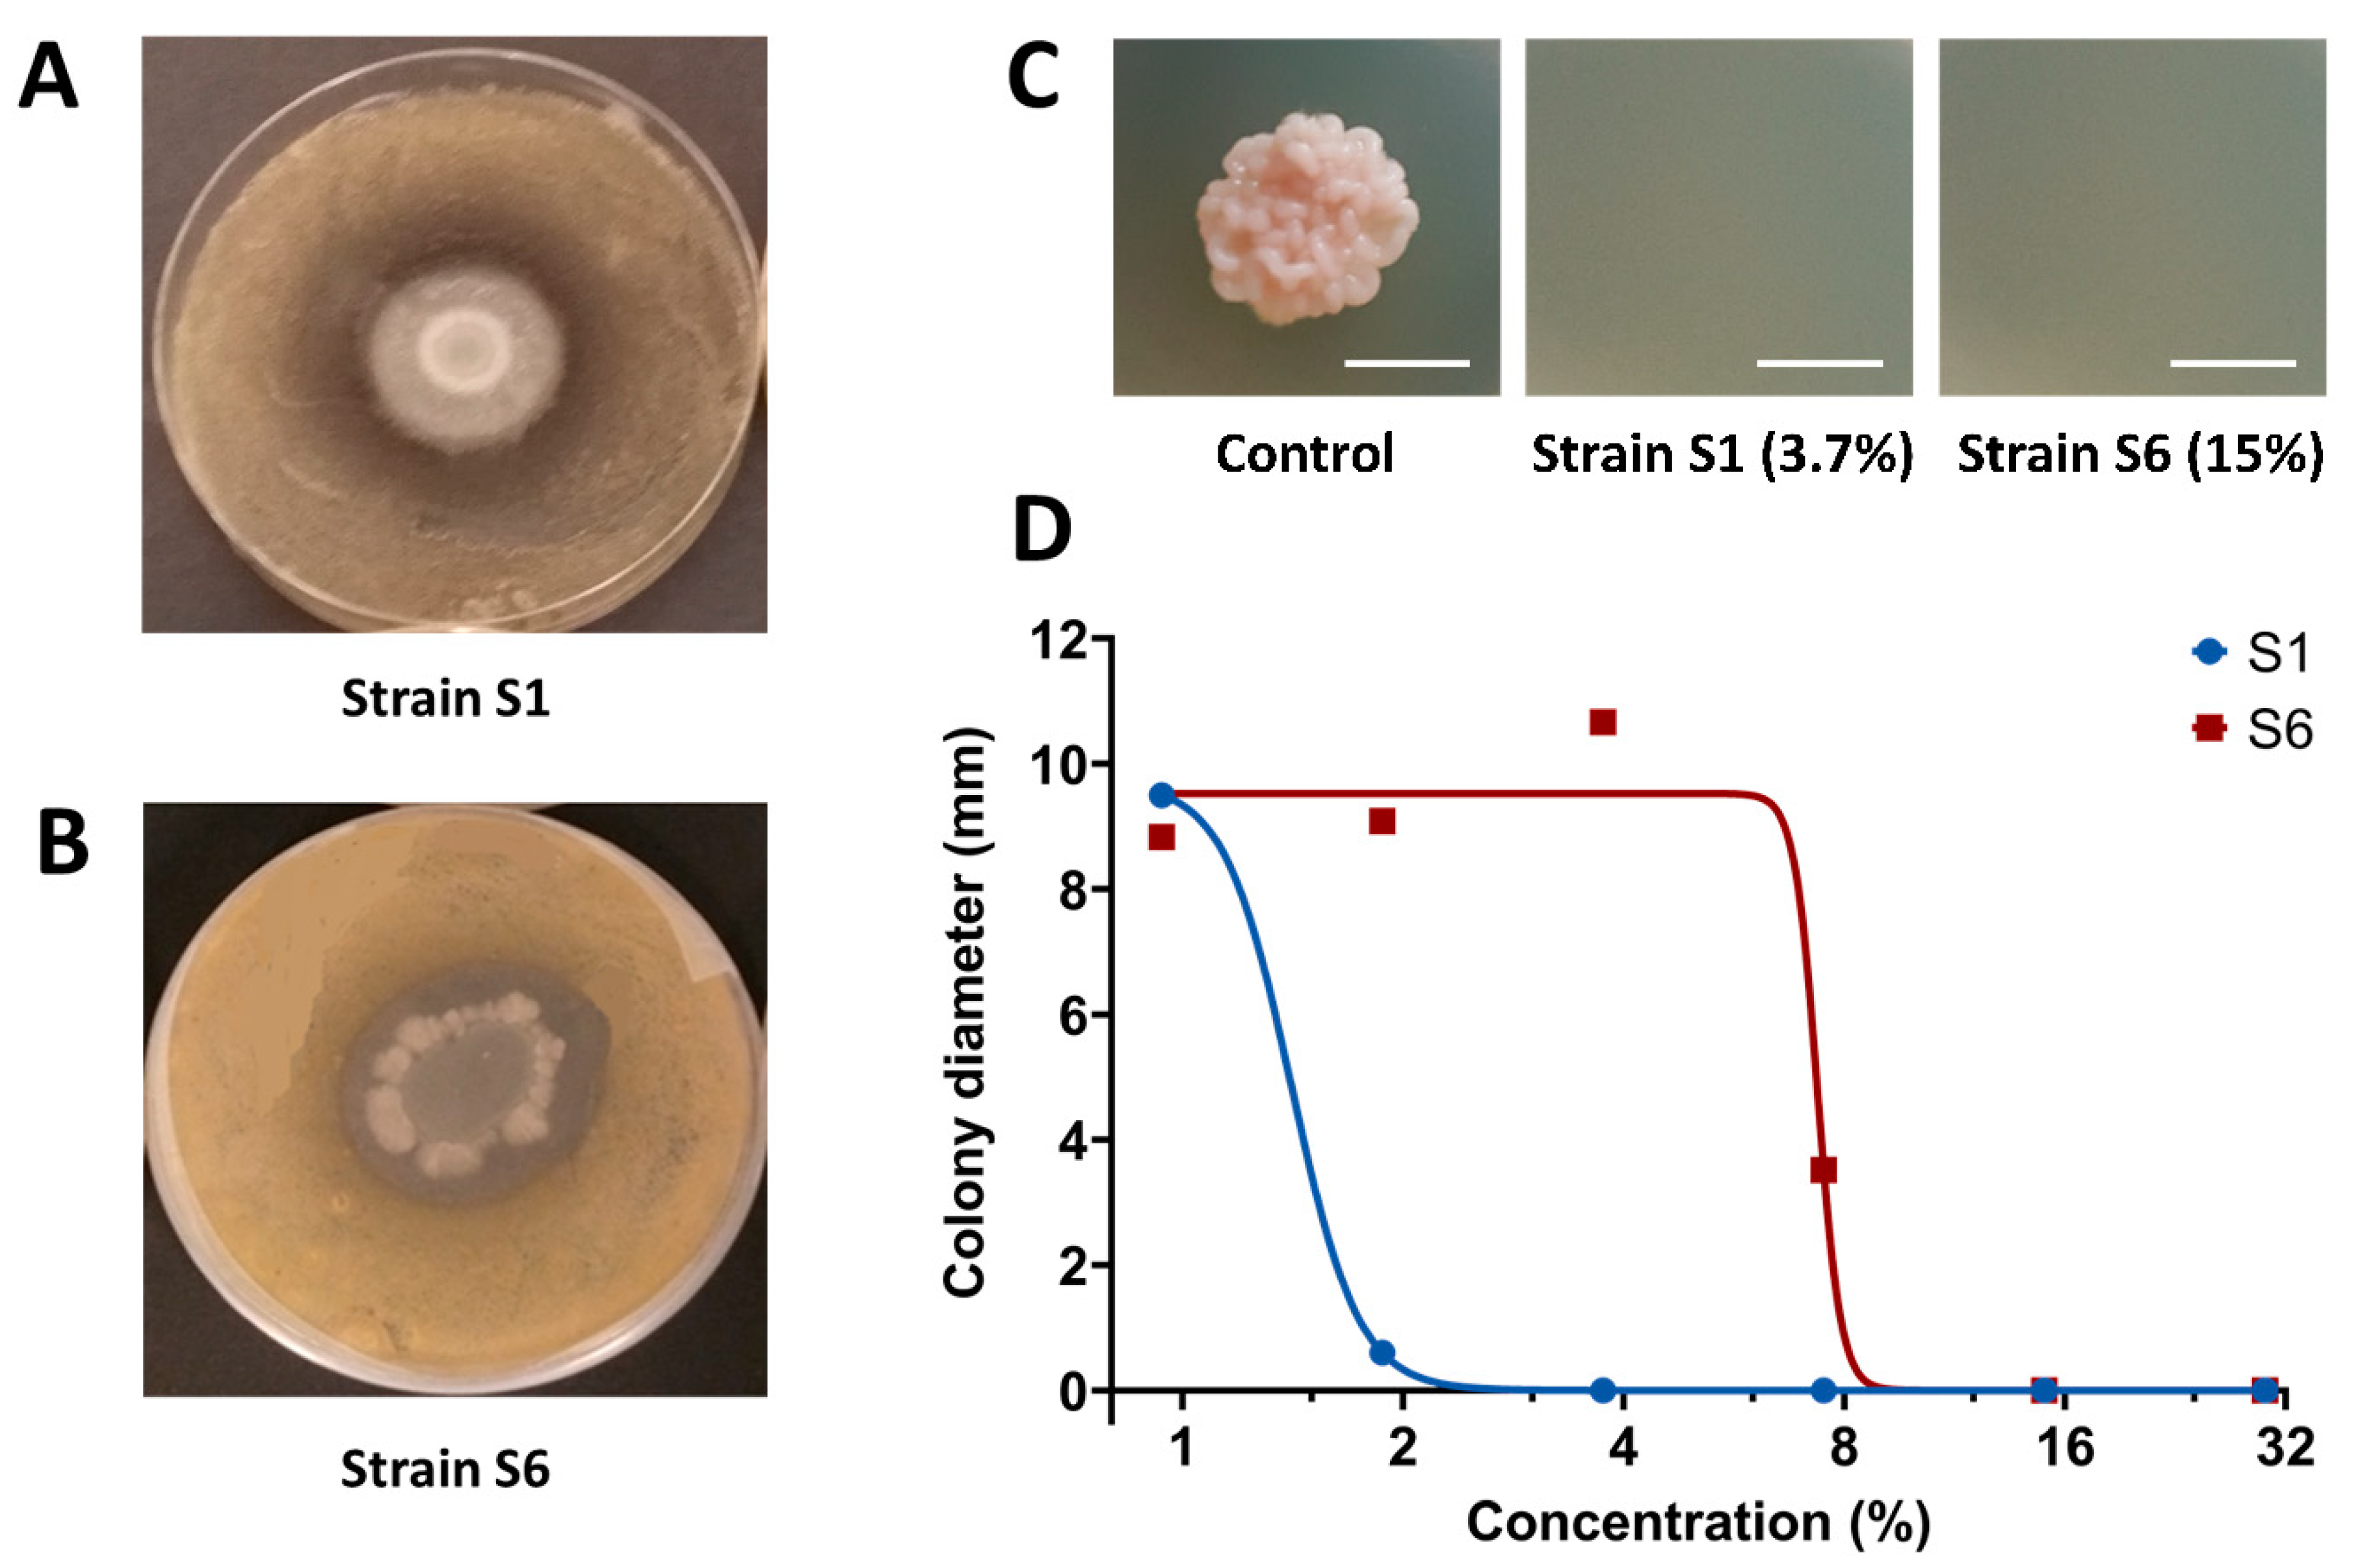
Agronomy 12 00095 g002 550

Isolation and Identification of Lipopeptide-Producing Bacillus velezensis Strains from Wheat Phyllosphere with Antifungal Activity against the Wheat Pathogen Zymoseptoria tritici
Abstract
:1. Introduction
2. Materials and Methods
2.1. Bacillus sp. Strain Isolation and Growth on Different Nutrient Media
2.2. Molecular Identification of S1 and S6 Strains
2.3. Culture Filtrate Production and Preparation
2.4. In Vitro Bacterial Antagonism Activity and Antifungal Activity Bioassays of Culture Filtrates
2.5. MALDI—ToF Assay
3. Results
3.1. S1 and S6 Strains Are New Unique B. velezensis Genotypes
3.2. S1 Strain Shows Stronger Direct In Vitro Antifungal Activity towards Z. tritici Compared to S6 Strain
3.3. Both S1 and S6 Strains Produce Cyclic Lipopeptides but with Distinct Patterns
4. Discussion
Supplementary Materials
Author Contributions
Funding
Acknowledgments
Conflicts of Interest
References
- Bhandari, V.; Ahmod, N.Z.; Shah, H.N.; Gupta, R.S. Molecular Signatures for Bacillus Species: Demarcation of the Bacillus subtilis and Bacillus cereus Clades in Molecular Terms and Proposal to Limit the Placement of New Species into the Genus Bacillus. Int. J. Syst. Evol. Microbiol. 2013, 63, 2712–2726. [Google Scholar] [CrossRef]
- Fan, B.; Blom, J.; Klenk, H.-P.; Borriss, R. Bacillus amyloliquefaciens, Bacillus velezensis, and Bacillus siamensis Form an “Operational Group B. amyloliquefaciens” within the B. subtilis Species Complex. Front. Microbiol. 2017, 8, 22. [Google Scholar] [CrossRef] [Green Version]
- Hamley, I.W. Lipopeptides: From Self-Assembly to Bioactivity. Chem. Commun. 2015, 51, 8574–8583. [Google Scholar] [CrossRef] [Green Version]
- Strieker, M.; Tanović, A.; Marahiel, M.A. Nonribosomal Peptide Synthetases: Structures and Dynamics. Curr. Opin. Struct. Biol. 2010, 20, 234–240. [Google Scholar] [CrossRef]
- Deravel, J.; Lemière, S.; Coutte, F.; Krier, F.; Van Hese, N.; Béchet, M.; Sourdeau, N.; Höfte, M.; Leprêtre, A.; Jacques, P. Mycosubtilin and Surfactin Are Efficient, Low Ecotoxicity Molecules for the Biocontrol of Lettuce Downy Mildew. Appl. Microbiol. Biotechnol. 2014, 98, 6255–6264. [Google Scholar] [CrossRef]
- Xun-Chao, C.; Hui, L.; Ya-Rong, X.; Chang-Hong, L. Study of Endophytic Bacillus amyloliquefaciens CC09 and Its Antifungal Cyclic Lipopeptides. J. Appl. Biol. Biotechnol. 2013, 1, 1–5. [Google Scholar] [CrossRef]
- Guo, Q.; Dong, W.; Li, S.; Lu, X.; Wang, P.; Zhang, X.; Wang, Y.; Ma, P. Fengycin Produced by Bacillus subtilis NCD-2 Plays a Major Role in Biocontrol of Cotton Seedling Damping-off Disease. Microbiol. Res. 2014, 169, 533–540. [Google Scholar] [CrossRef]
- Romero, D.; de Vicente, A.; Rakotoaly, R.H.; Dufour, S.E.; Veening, J.-W.; Arrebola, E.; Cazorla, F.M.; Kuipers, O.P.; Paquot, M.; Pérez-García, A. The Iturin and Fengycin Families of Lipopeptides Are Key Factors in Antagonism of Bacillus subtilis toward Podosphaera fusca. Mol. Plant Microbe Interact. 2007, 20, 430–440. [Google Scholar] [CrossRef] [Green Version]
- Jacques, P. Surfactin and Other Lipopeptides from Bacillus spp. In Biosurfactants: From Genes to Applications; Soberón-Chávez, G., Ed.; Microbiology Monographs; Springer: Berlin/Heidelberg, Germany, 2011; pp. 57–91. ISBN 978-3-642-14490-5. [Google Scholar]
- Crouzet, J.; Arguelles-Arias, A.; Dhondt-Cordelier, S.; Cordelier, S.; Pršić, J.; Hoff, G.; Mazeyrat-Gourbeyre, F.; Baillieul, F.; Clément, C.; Ongena, M.; et al. Biosurfactants in Plant Protection Against Diseases: Rhamnolipids and Lipopeptides Case Study. Front. Bioeng. Biotechnol. 2020, 8. [Google Scholar] [CrossRef]
- Fira, D.; Dimkić, I.; Berić, T.; Lozo, J.; Stanković, S. Biological Control of Plant Pathogens by Bacillus Species. J. Biotechnol. 2018, 285, 44–55. [Google Scholar] [CrossRef]
- Ponomarenko, A.; Goodwin, S.B.; Kema, G.H.J. Septoria Tritici Blotch (STB) of Wheat. In Plant Health Instructor; American Phytopathological Society: St. Paul, MI, USA; p. 2011. [CrossRef]
- Fones, H.; Gurr, S. The Impact of Septoria Tritici Blotch Disease on Wheat: An EU Perspective. Fungal Genet. Biol. 2015, 79, 3–7. [Google Scholar] [CrossRef] [Green Version]
- Siah, A.; Deweer, C.; Duyme, F.; Sanssené, J.; Durand, R.; Halama, P.; Reignault, P. Correlation of in Planta Endo-Beta-1,4-Xylanase Activity with the Necrotrophic Phase of the Hemibiotrophic Fungus Mycosphaerella graminicola. Plant Pathol. 2010, 59, 661–670. [Google Scholar] [CrossRef]
- Lovell, D.J.; Hunter, T.; Powers, S.J.; Parker, S.R.; Bosch, F.V. den Effect of Temperature on Latent Period of Septoria Leaf Blotch on Winter Wheat under Outdoor Conditions. Plant Pathol. 2004, 53, 170–181. [Google Scholar] [CrossRef]
- Cowger, C.; Hoffer, M.E.; Mundt, C.C. Specific Adaptation by Mycosphaerella graminicola to a Resistant Wheat Cultivar. Plant Pathol. 2000, 49, 445–451. [Google Scholar] [CrossRef]
- Cheval, P.; Siah, A.; Bomble, M.; Popper, A.D.; Reignault, P.; Halama, P. Evolution of QoI Resistance of the Wheat Pathogen Zymoseptoria tritici in Northern France. Crop Prot. 2017, 92, 131–133. [Google Scholar] [CrossRef]
- Beneduzi, A.; Ambrosini, A.; Passaglia, L.M.P. Plant Growth-Promoting Rhizobacteria (PGPR): Their Potential as Antagonists and Biocontrol Agents. Genet. Mol. Biol. 2012, 35, 1044–1051. [Google Scholar] [CrossRef] [Green Version]
- Landy, M.; Warren, G.H.; RosenmanM, S.B.; Colio, L.G. Bacillomycin: An Antibiotic from Bacillus subtilis Active against Pathogenic Fungi. Proc. Soc. Exp. Biol. Med. 1948, 67, 539–541. [Google Scholar] [CrossRef]
- Esmaeel, Q.; Jacquard, C.; Sanchez, L.; Clément, C.; Ait Barka, E. The Mode of Action of Plant Associated Burkholderia against Grey Mould Disease in Grapevine Revealed through Traits and Genomic Analyses. Sci Rep. 2020, 10, 19393. [Google Scholar] [CrossRef]
- Kumar, S.; Stecher, G.; Li, M.; Knyaz, C.; Tamura, K. MEGA X: Molecular Evolutionary Genetics Analysis across Computing Platforms. Mol. Biol. Evol. 2018, 35, 1547–1549. [Google Scholar] [CrossRef]
- Platel, R.; Chaveriat, L.; Le Guenic, S.; Pipeleers, R.; Magnin-Robert, M.; Randoux, B.; Trapet, P.; Lequart, V.; Joly, N.; Halama, P.; et al. Importance of the C12 Carbon Chain in the Biological Activity of Rhamnolipids Conferring Protection in Wheat against Zymoseptoria tritici. Molecules 2021, 26, 40. [Google Scholar] [CrossRef]
- Ongena, M.; Jacques, P. Bacillus Lipopeptides: Versatile Weapons for Plant Disease Biocontrol. Trends Microbiol. 2008, 16, 115–125. [Google Scholar] [CrossRef]
- Gu, Q.; Yang, Y.; Yuan, Q.; Shi, G.; Wu, L.; Lou, Z.; Huo, R.; Wu, H.; Borriss, R.; Gao, X. Bacillomycin D Produced by Bacillus amyloliquefaciens Is Involved in the Antagonistic Interaction with the Plant-Pathogenic Fungus Fusarium graminearum. Appl. Environ. Microbiol. 2017, 83. [Google Scholar] [CrossRef] [Green Version]
- Abderrahmani, A.; Tapi, A.; Nateche, F.; Chollet, M.; Leclère, V.; Wathelet, B.; Hacene, H.; Jacques, P. Bioinformatics and Molecular Approaches to Detect NRPS Genes Involved in the Biosynthesis of Kurstakin from Bacillus thuringiensis. Appl. Microbiol. Biotechnol. 2011, 92, 571–581. [Google Scholar] [CrossRef]
- Allioui, N.; Driss, F.; Dhouib, H.; Jlail, L.; Tounsi, S.; Frikha-Gargouri, O. Two Novel Bacillus Strains (Subtilis and Simplex Species) with Promising Potential for the Biocontrol of Zymoseptoria tritici, the Causal Agent of Septoria Tritici Blotch of Wheat. BioMed Res. Int. 2021, 2021, 6611657. [Google Scholar] [CrossRef]
- Rabbee, M.F.; Ali, M.S.; Choi, J.; Hwang, B.S.; Jeong, S.C.; Baek, K. Bacillus velezensis: A Valuable Member of Bioactive Molecules within Plant Microbiomes. Molecules 2019, 24, 1046. [Google Scholar] [CrossRef] [Green Version]
- Chen, J.; Wu, Q.; Hua, Y.; Chen, J.; Zhang, H.; Wang, H. Potential Applications of Biosurfactant Rhamnolipids in Agriculture and Biomedicine. Appl. Microbiol. Biotechnol. 2017, 101, 8309–8319. [Google Scholar] [CrossRef]
- Pérez-García, A.; Romero, D.; de Vicente, A. Plant Protection and Growth Stimulation by Microorganisms: Biotechnological Applications of Bacilli in Agriculture. Curr. Opin. Biotechnol. 2011, 22, 187–193. [Google Scholar] [CrossRef]
- Koumoutsi, A.; Chen, X.-H.; Henne, A.; Liesegang, H.; Hitzeroth, G.; Franke, P.; Vater, J.; Borriss, R. Structural and Functional Characterization of Gene Clusters Directing Nonribosomal Synthesis of Bioactive Cyclic Lipopeptides in Bacillus amyloliquefaciens Strain FZB42. J. Bacteriol. 2004, 186, 1084–1096. [Google Scholar] [CrossRef] [Green Version]
- Chen, X.H.; Koumoutsi, A.; Scholz, R.; Schneider, K.; Vater, J.; Süssmuth, R.; Piel, J.; Borriss, R. Genome Analysis of Bacillus amyloliquefaciens FZB42 Reveals Its Potential for Biocontrol of Plant Pathogens. J. Biotechnol. 2009, 140, 27–37. [Google Scholar] [CrossRef]
- Xu, Z.; Shao, J.; Li, B.; Yan, X.; Shen, Q.; Zhang, R. Contribution of Bacillomycin D in Bacillus amyloliquefaciens SQR9 to Antifungal Activity and Biofilm Formation. Appl. Environ. Microbiol. 2013, 79, 808–815. [Google Scholar] [CrossRef] [Green Version]
- Cao, Y.; Pi, H.; Chandrangsu, P.; Li, Y.; Wang, Y.; Zhou, H.; Xiong, H.; Helmann, J.D.; Cai, Y. Antagonism of Two Plant-Growth Promoting Bacillus velezensis Isolates Against Ralstonia solanacearum and Fusarium oxysporum. Sci. Rep. 2018, 8, 4360. [Google Scholar] [CrossRef]
- Mejri, S.; Siah, A.; Coutte, F.; Magnin-Robert, M.; Randoux, B.; Tisserant, B.; Krier, F.; Jacques, P.; Reignault, P.; Halama, P. Biocontrol of the Wheat Pathogen Zymoseptoria tritici Using Cyclic Lipopeptides from Bacillus subtilis. Environ. Sci. Pollut. Res. 2018, 25, 29822–29833. [Google Scholar] [CrossRef]
- Leclère, V.; Béchet, M.; Adam, A.; Guez, J.-S.; Wathelet, B.; Ongena, M.; Thonart, P.; Gancel, F.; Chollet-Imbert, M.; Jacques, P. Mycosubtilin Overproduction by Bacillus subtilis BBG100 Enhances the Organism’s Antagonistic and Biocontrol Activities. Appl. Environ. Microbiol. 2005, 71, 4577–4584. [Google Scholar] [CrossRef] [Green Version]
- Moyne, A.L.; Shelby, R.; Cleveland, T.E.; Tuzun, S. Bacillomycin D: An Iturin with Antifungal Activity against Aspergillus flavus. J. Appl. Microbiol. 2001, 90, 622–629. [Google Scholar] [CrossRef]
- Chowdhury, S.P.; Hartmann, A.; Gao, X.; Borriss, R. Biocontrol Mechanism by Root-Associated Bacillus amyloliquefaciens FZB42—A Review. Front. Microbiol. 2015, 6, 780. [Google Scholar] [CrossRef] [Green Version]

| Bacillus velezensis S1 | ||
|---|---|---|
| m/z | Putative Assigned Lipopeptide | Lipopeptide Family |
| 1044.8 | Surfactin C14 or [Val7] Pumilacidin C14 [M + Na]+ | Surfactin |
| 1058.8 | Surfactin C15 or [Val7] Pumilacidin C15 [M + Na]+ | Surfactin |
| 1074.8 | Surfactin C15 or [Val7] Pumilacidin C15 [M + K]+ | Surfactin |
| 1053.6 | Bacillomycin D C14 [M + Na]+ | Iturin |
| 1067.7 | Bacillomycin D C15 [M + Na]+ | Iturin |
| 1083.7 | Bacillomycin D C15 [M + K]+ | Iturin |
| 1081.7 | Bacillomycin D C16 [M + Na]+ | Iturin |
| 1095.7 | Bacillomycin D C17 [M + Na]+ | Iturin |
| 1486.0 | Fengycin A C16 [M + Na]+ or Fengycin A C15 (insat) [M + K]+ | Fengycin |
| 1499.8 | Fengycin A C17 [M + Na]+ or Fengycin AC16 (insat) [M + K]+ [M + Na]+ | Fengycin |
| Bacillus velezensis S6 | ||
| m/z | Putative Assigned Lipopeptide | Lipopeptide Family |
| 1030.8 | Surfactin C13 or [Val7] Pumilacidin C13 [M + Na]+ | Surfactin |
| 1044.8 | Surfactin C14 or [Val7] Pumilacidin C14 [M + Na]+ | Surfactin |
| 1058.8 | Surfactin C15 or [Val7] Pumilacidin C15 [M + Na]+ | Surfactin |
| 1065.6 | Iturin A C14 or Mycosubtilin C14 [M + Na]+ | Iturin |
| 1079.6 | Iturin A C15 or Mycosubtilin C15 [M + Na]+ | Iturin |
| 1095.6 | Iturin A C15 or Mycosubtilin C15 [M + K]+ | Iturin |
| 1093.6 | Iturin A C16 or Mycosubtilin C16 [M + Na]+ | Iturin |
| 1109.6 | Iturin A C16 or Mycosubtilin C16 [M + K]+ | Iturin |
| 1107.6 | Iturin A C17 or Mycosubtilin C17 [M + Na]+ | Iturin |
Publisher’s Note: MDPI stays neutral with regard to jurisdictional claims in published maps and institutional affiliations. |
© 2021 by the authors. Licensee MDPI, Basel, Switzerland. This article is an open access article distributed under the terms and conditions of the Creative Commons Attribution (CC BY) license (https://creativecommons.org/licenses/by/4.0/).
Share and Cite
Platel, R.; Sawicki, M.; Esmaeel, Q.; Randoux, B.; Trapet, P.; El Guilli, M.; Chtaina, N.; Arnauld, S.; Bricout, A.; Rochex, A.; et al. Isolation and Identification of Lipopeptide-Producing Bacillus velezensis Strains from Wheat Phyllosphere with Antifungal Activity against the Wheat Pathogen Zymoseptoria tritici. Agronomy 2022, 12, 95. https://doi.org/10.3390/agronomy12010095
Platel R, Sawicki M, Esmaeel Q, Randoux B, Trapet P, El Guilli M, Chtaina N, Arnauld S, Bricout A, Rochex A, et al. Isolation and Identification of Lipopeptide-Producing Bacillus velezensis Strains from Wheat Phyllosphere with Antifungal Activity against the Wheat Pathogen Zymoseptoria tritici. Agronomy. 2022; 12(1):95. https://doi.org/10.3390/agronomy12010095
Chicago/Turabian StylePlatel, Rémi, Mélodie Sawicki, Qassim Esmaeel, Béatrice Randoux, Pauline Trapet, Mohammed El Guilli, Noureddine Chtaina, Ségolène Arnauld, Alexandre Bricout, Alice Rochex, and et al. 2022. "Isolation and Identification of Lipopeptide-Producing Bacillus velezensis Strains from Wheat Phyllosphere with Antifungal Activity against the Wheat Pathogen Zymoseptoria tritici" Agronomy 12, no. 1: 95. https://doi.org/10.3390/agronomy12010095
APA StylePlatel, R., Sawicki, M., Esmaeel, Q., Randoux, B., Trapet, P., El Guilli, M., Chtaina, N., Arnauld, S., Bricout, A., Rochex, A., Bourdon, N., Halama, P., Jacquard, C., Barka, E. A., Reignault, P., Magnin-Robert, M., & Siah, A. (2022). Isolation and Identification of Lipopeptide-Producing Bacillus velezensis Strains from Wheat Phyllosphere with Antifungal Activity against the Wheat Pathogen Zymoseptoria tritici. Agronomy, 12(1), 95. https://doi.org/10.3390/agronomy12010095

